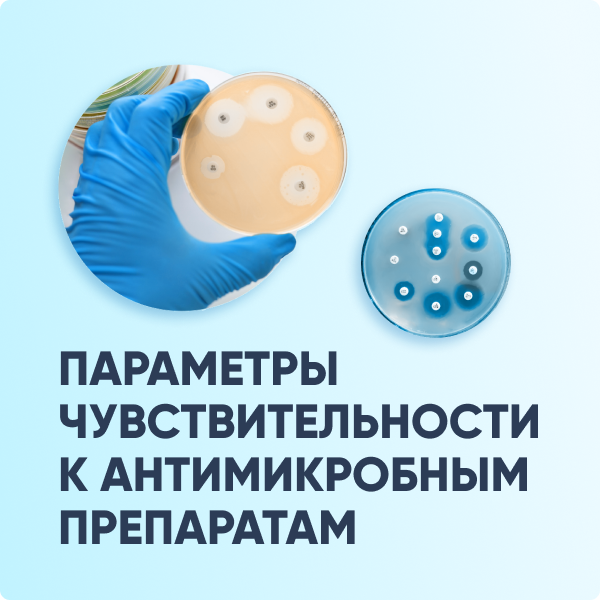
Параметры чувствительности к антимикробным препаратам

ФСЛИ
Федеральный справочник лабораторных исследований
ФСЛИ
Группа классификаторов Федерального реестра НСИ Минздрава России
Единые стандарты для здравоохранения
ФСЛИ подготовлен для стандартизации терминологии и наименований, а также системы кодирования клинико-лабораторных данных.
Обеспечивают обмен данными в унифицированном виде по всей системе здравоохранения России.
Результат
- Сопоставление результатов исследований
- Упрощение подготовки отчетности
- Единый стандарт для всех лабораторий

Справочник лабораторных тестов
Все тесты обладают уникальным семизначным кодом и сгруппированы по следующим показателям: измеряемый аналит и его характеристики; размерность и единицы измерения; вид лабораторного образца; метод измерения; тип шкалы результата; временная характеристика продолжительности исследования.

Группы лабораторных исследований
Каждому виду лабораторных исследований присвоен уникальный идентификатор.

Справочник лабораторных материалов и образцов
Образцам и материалам присвоен уникальный код, при этом одному материалу может соответствовать несколько образцов.

Профили лабораторных исследований
Каждому профилю исследований присвоен уникальный код и указан его код номенклатуры медицинских услуг.

Справочник бактерий
Каждой записи присвоен уникальный код, указаны их полное наименование, окраска по Граму, код SNOMED CT, этиологически значимые агенты заболеваний у человека, код NCBI, синонимы.

Справочник грибов
Записям присвоен уникальный идентификатор, полное наименование, синонимы, коды NCBI и SNOMED CT.

Справочник вирусов
Записи сгруппированы по рангу, им присвоен уникальный идентификатор, а также представлены полное название, синонимы, коды МКБ-10 и NCBI.

Справочник паразитов
Записям присвоен уникальный идентификатор, представлены полное название, синонимы, коды МКБ-10 и NCBI, ранг записи.
Параметры чувствительности к антимикробным препаратам
В справочнике представлены микроорганизмы (или их группы), идентификаторы бактерий, типы инфекций, пути введения, пограничные значения минимальной подавляющей концентрации и соответствующие им пограничные значения диаметров зон подавления роста по классификациям EUCAST и CLSI.

Маркеры антибиотикорезистентности микроорганизмов
Каждый маркер описан с помощью уникального идентификатора, краткого и полного наименования на русском и английском, а также типа и кода белка NCBI.










